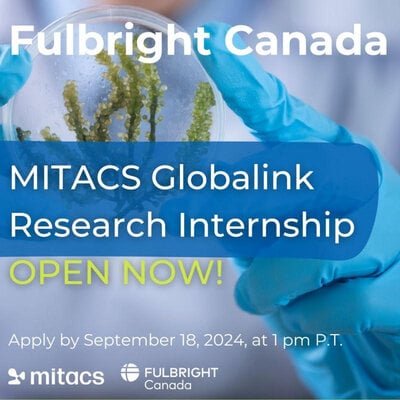

Application Deadline: September 18, 2024, at 1 pm P.T
Applications are now open for the 2025 Globalink Research Internship. Mitacs Globalink Research Internship is a competitive initiative for international undergraduates from the following countries and regions: Brazil, Chile, China, Colombia, France, Germany, Hong Kong, Mexico, Pakistan, Saudi Arabia, South Korea, Taiwan, Tunisia, Ukraine, United Kingdom and the United States. From May to October of each year, top-ranked applicants participate in a 12-week research internship under the supervision of Canadian academic institution faculty members in a variety of academic disciplines, from science, engineering, and mathematics to the humanities and social sciences.
Mitacs Globalink Research Internships can offer you an international experience like no other. Canada features excellent universities, outstanding research facilities, cutting-edge industry innovation, and unparalleled undergraduate training opportunities.
Eligibility
Eligibility requirements for 2025
Applicants must:
- Be at least 18 years of age at the time of application
- Be enrolled in a full-time undergraduate or combined undergraduate/master’s program at an eligible institution (see list of eligible institutions by country)
- Have one to three semesters remaining in their program as of fall 2025 (see requirement by country)
- Meet the grade requirements for their country of study (see GPA requirements for each international partner)
- Apply to a minimum of three and a maximum of ten projects and ensure selections are from at least three different Canadian provinces
- Be fluent in the oral and written language of the project (English and/or French)
- Be available to complete an internship lasting 12 consecutive weeks between May 1 and October 31. You must be able to start your internship anytime between May 1st and July 31st. Anything before or after those dates is not allowed.
- Not have been awarded a Globalink Research Internship project in the past
- Any applicant who is currently affiliated with, or in receipt of funding or in-kind support from one or more of the institutions on the list of NROs is not eligible to participate in a Mitacs-funded project involving research that aims to advance a Sensitive Technology Research Area (STRA). Mitacs will also screen a sample of applications, selected at its sole discretion, and validate the accuracy of the completed declarations. Mitacs reserves the right to decline funding, at any point, for a project that advances a sensitive technology research area because of affiliations of concern.
Benefits
- A 12-week internship that increases your knowledge of and explores hands-on research in your field of study
- Work under the supervision of outstanding faculty members, with graduate students and research associates
- Access to Canada’s unique research landscape: applied, dynamic, and innovative
- A rewarding experience combining academic research at a Canadian academic institution, professional skills development courses and social activities
- A chance for you to explore your independence and gain international experience in a new country
How to Apply
Mitacs encourages you to start working on the following items before the call opens:
- Review all eligibility criteria: in addition to the general GRI requirements, there may be specific eligibility criteria for each country and international partner organization.
- Confirm that your passport issued by your home country is valid until at least January 2026. (You are welcome to submit an application if you don’t currently have a valid passport. However, you will need to provide valid passport information if your application is approved).
- Obtain a reference letter from a professor. Please refer to the reference-letter instructions in the downloadable Globalink Research Internship Information zip file. All reference letters must follow the instructions provided.
- Update your CV: You can submit your own CV or use the CV template in the downloadable Globalink Research Internship Information zip file.
- Obtain your academic transcripts (in either English or French). If your academic institution cannot provide transcripts in either language, you are responsible for getting them translated and notarized. Transcripts must be included in your application.
- English or French language-proficiency tests may be required for some countries. Please check your country’s details for more information.
In the application, you will also be asked about:
- Your academic discipline, program, and other educational information
- Your research interests, skills, and achievements
- Your reasons for pursuing research in Canada
For More Information:
Visit the Official Webpage of the Globalink Research Internship